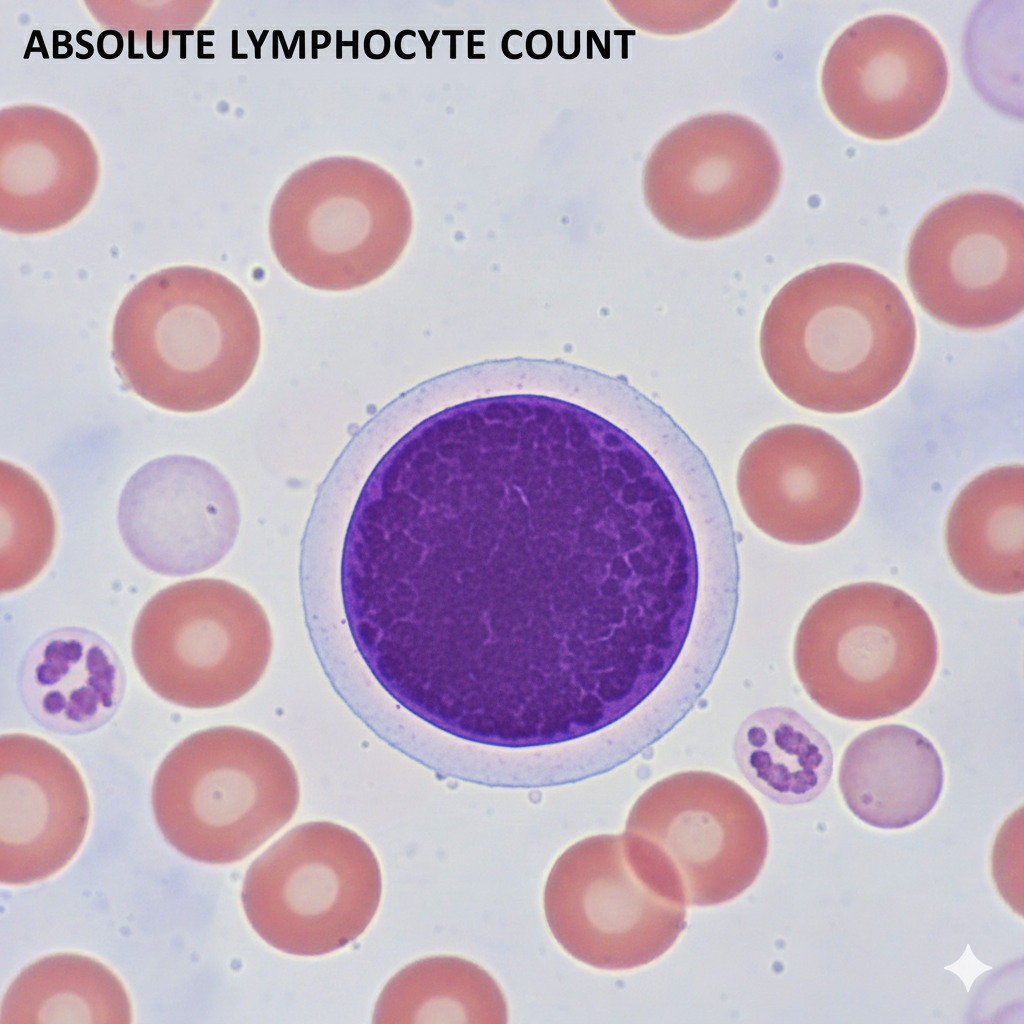
Absolute Lymphocyte Count (ALC)

Sale!
Uncategorized
Absolute Lymphocyte Count (ALC)
₹437.00 Original price was: ₹437.00.₹175.00Current price is: ₹175.00.
Category: Uncategorized
Related products
-
Uncategorized
Urine For Calcium(24 Hours)
₹599.00Original price was: ₹599.00.₹499.00Current price is: ₹499.00. -
Uncategorized
Serotonin (5-HT)
₹5,300.00Original price was: ₹5,300.00.₹4,120.00Current price is: ₹4,120.00. -
Uncategorized
Absolute Neutrophilic Count (ANC)
₹437.00Original price was: ₹437.00.₹175.00Current price is: ₹175.00. -
Uncategorized
Urine Copper (24 Hours)
₹2,100.00Original price was: ₹2,100.00.₹1,999.00Current price is: ₹1,999.00.